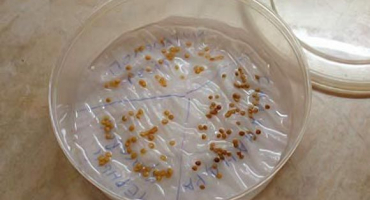
Jak můžete zkontrolovat a určit klíčivost semen rajčat?

Jak doma otestovat klíčivost semen okurek ve vodě
Obsah
Před výsevem sazenic zeleniny se musí mnoho pěstitelů zeleniny rozhodnout, jak otestovat klíčivost semen okurek. To platí zejména pro semena sklizená nezávisle.
Zkušení šlechtitelé semen se zabývají pěstováním a výběrem semen od výrobních společností.
Osivo v průmyslových podmínkách:
- kalibrovat;
- zahřát se;
- ošetřené fungicidy;
- namočené v růstových stimulantech.
Kupovaná semena proto většinou nepotřebují předseťovou přípravu a zkoušení klíčivosti, ale jsou poměrně drahá. Pokud odrůda okurek, která se vám líbí, není hybridní (na obalu nebylo označení F1), pak není vůbec těžké sbírat semeno doma. Ale před výsadbou bude muset být testována na klíčivost. Zvláště pokud si nejste jisti podmínkami skladování.

Odmítnutí semen
Klíčivost je procento zdravého semene v jedné dávce, které produkuje dobře vyvinuté sazenice.
Před kontrolou klíčivosti semen okurek lze prázdná semena vyhodit do vody. Nejsou schopni dávat normální výhonky.

Za tímto účelem se semeno nalije po malých částech teplou vodou a nechá se stát 8-10 minut. Nízká semena s nedostatečnou energií klíčení vyplavou na povrch. Nejsou vhodné pro pěstování zdravých rostlin a vyhazují se.
Semena zbývající na dně se suší a třídí. Všechny by měly mít přibližně stejnou velikost a barvu, ty nejmenší by měly být také odstraněny.

Skladování a klíčení
Důležité!
Příští rok se nedoporučuje sázet semena okurek, protože posklizňové zrání semene této plodiny trvá 2-3 roky.
Během této doby některé patogenní organismy v semenech zemřou, například virus mozaiky okurky. Rostliny vypěstované z jednoletého výsevního materiálu mají tendenci se hůře větvit a tvoří převážně „samčí“ květenství. Na suchém a teplém místě zůstává výsevní materiál okurek životaschopný až 6-8 let. Po čtvrtém roce skladování je však nutné zkontrolovat klíčivost semen, protože energie klíčení bude postupně klesat.

Pokud semeno skladujete na vlhkém a chladném místě, pak hrozí vypěstování rostlin s dlouhými řasami a převážně samčím kvetením.
Po dlouhé době hledání semen okurek ve špatných podmínkách je potřeba je očichat. Vůně by měla být bez zatuchlých a žluklých nečistot. Protože je to známka vývoje patogenních bakterií a hub v semenech.

Zkouška klíčení
Existuje několik způsobů, jak testovat klíčivost:
- klíčení ve filtračním papíru;
- klíčení v pilinách;
- klíčení v papírové roli.

Klíčení v papíru
Několik vrstev filtračního papíru se navlhčí teplou vodou a semena se rozprostírají v krátké vzdálenosti od sebe. Aby bylo možné provádět výpočty později, je nutné spočítat všechna semena. Vršek přikryjte další vrstvou papíru a dejte na teplé místo s teplotou 26-27 ℃. Několikrát denně jsou zásobníky papíru kontrolovány a navlhčeny suchými ubrousky.
Po 3-4 dnech se objeví první výhonky okurek. Tato semena měla nejvyšší energii klíčení. Sprinter klíčky budou produkovat nejzdravější a nejproduktivnější keře. Výrobní podniky proto věnují pozornost stanovení energie klíčení a odrůdy v popisu charakterizují ukazatelem přátelství a rychlosti klíčení. Energie klíčení se rovná procentu naklíčených okurek během prvních 3-4 dnů k celkovému množství semen.

Všechna živá semena by měla vyklíčit za 6-7 dní. Spočítejte počet zdravých výhonků a vypočítejte procento z celkového inokula. Výsadba okurek s klíčivostí nižší než 60% je považována za nerentabilní.
I když se po 7 dnech mezi semeny, která nevyklíčila, najdou semena, která se vylíhla, nejsou započítána a odmítnuta. Čím déle semeno v půdě neklíčí, tím více negativních faktorů je vystaveno.

Klíčení v pilinách
Před kontrolou klíčivosti semen se piliny spaří vroucí vodou. Poté se do krabice nalije vrstva 5-6 cm. Spočítané okurky jsou rozloženy ve vzdálenosti 1-2 cm. Navrch nasypte 2-3 cm spařených pilin a udusejte. Zásuvku lze pokrýt průhlednou fólií, aby se zabránilo vysychání.
Krabice je umístěna na teplém, světlém místě 25-26 ℃. Okurky budou rašit ve tmě, ale bylo zjištěno, že na světlém místě se výhonky objevují dříve a zdravěji. Další výpočty se provádějí stejným způsobem jako u metody s papírem.

Klíčení v papírové roli
Dvě vrstvy porézního volného papíru o rozměrech 10 × 100 cm se navlhčí vodou. Ustoupí od horního okraje o 2–3 cm a rozloží semeno do řady ve vzdálenosti 1,5–2 cm s embryi dolů. Poté přikryjeme stejnou třetí vrstvou papíru a srolujeme do volné rolky, kterou svisle položíme do vhodné misky.
Klíčení okurek by mělo probíhat na světlém a teplém místě. Papír je při sušení navlhčen. Po 7 dnech se role opatrně rozvine, spočítají se zdravé výhonky a vypočítá se procento klíčivosti.

Zahřívání a zpracování pomocí růstových stimulantů
Před stanovením klíčivosti semen je lze připravit. Zahřívání semen a ošetření růstovými stimulanty zvyšují energii klíčení, urychlují růst vegetativní hmoty, zlepšují vývoj kořenového systému budoucích rostlin. Kupované okurky jsou většinou předpřipravené ve výrobě.
Existují dva typy ohřevu semen:
- suché vytápění;
- zahřívání ve vodě.

První metoda je potřeba především pro „mladá“ semena sklizená v loňském roce.
Rada!
Suché vytápění v plátěném sáčku na radiátoru při teplotě 50-60 ℃ po dobu jednoho měsíce vám umožní oklamat přírodu a zahájit proces „stárnutí“.
Zahřátí v teplé vodě 50-60 ℃ po dobu 30 minut před výsevem umožňuje rychle probudit okurky a je užitečné pro zvýšení energie klíčení a klíčení.

Tyto chemikálie a vitamíny jsou známé pro zpracování semenného materiálu před setím (na 100 ml vody):
- humát sodný - 10-20 mg;
- kyselina jantarová - 0,4 mg;
- heteroauxin - 50 mg;
- kyselina nikotinová - 10 mg;
- thiamin - 10 mg.
Objem roztoku by měl být 2krát větší než objem semen, teplota je 17-18 ℃. Semeno se máčí po dobu 6-12 hodin, poté se dobře promyje a suší.